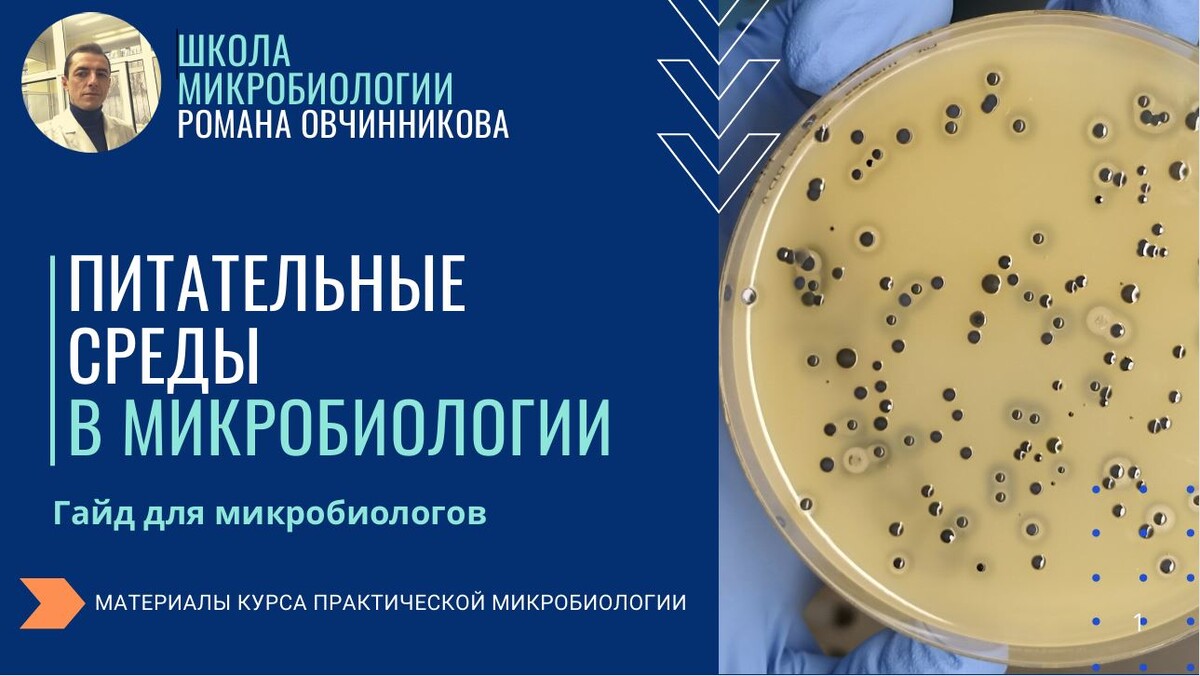
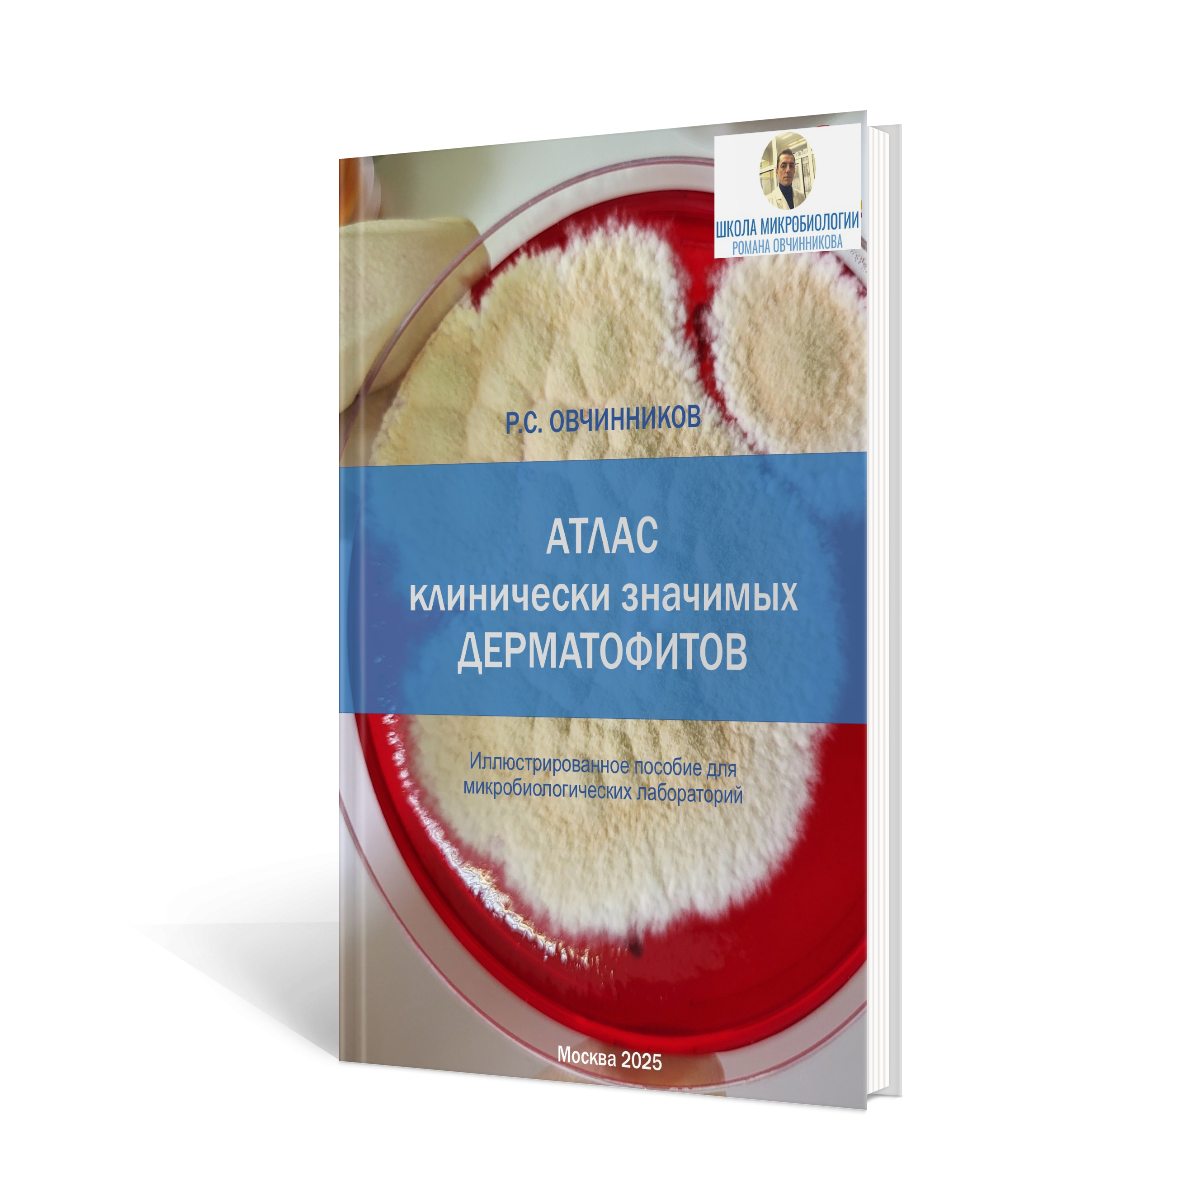

авторские материалы по микробиологии Романа Овчинникова
PDF-гайды и методические материалы для микробиологов
Чем эти гайды и методички отличаются от "официальных" учебников и пособий?
- Практическая направленность - мои гайды и методички созданы, чтобы помочь микробиологам в практической лабораторной работе;
- Опыт из первых рук - основаны на собственном многолетнем опыте работы в микробиологии;
- Наглядность - все материалы хорошо иллюстрированы авторскими фотографиями;
- Доступное изложение материала - понятно даже начинающим микробиологам.
- Актуальность, современность, удобный формат.
Бесплатные PDF-гайды
Новый формат учебных материалов для практиков
Питательные среды в микробиологии. Практический гайд
Это уникальное практическое руководство, которое даст вам знания и навыки, недоступные в стандартных учебниках! Этот гайд предлагает рабочие решения и охватывает вопросы:
• Типы питательных сред: Понятный обзор универсальных, селективных, дифференциальных и других сред, с акцентом на их реальное применение и особенности, которые нужно знать на практике.
• Алгоритм выбора: Простой и эффективный алгоритм подбора оптимальной среды, учитывающий рабочие условия и диагностические задачи, а не только абстрактную теорию.
• Применение на практике: Четкое понимание, когда и где применять каждую среду, подкрепленное практическими примерами из реальной микробиологической работы.
Наш практический гайд идеально подходит для студентов, лаборантов и специалистов, которым важно практическое понимание вопроса.
Цена: бесплатно

Рекомендации по безопасности в баклаборатории
Практические правила и советы по работе в микробиологической лаборатории, основанные на многолетнем личном опыте. В методичке:
* Практические советы, напрямую применимые в вашей работе.
* Секреты безопасной практики: Рекомендации, которые помогут избежать рисков и обеспечить безопасность.
* Понятный язык: Легко усваивается, что важно для всех уровней подготовки.
Повышайте свою безопасность и профессионализм. Эта методичка – ваш помощник в уверенной работе с микроорганизмами.
Цена: бесплатно

Рекомендации по обращению и уходу за микроскопом
Подробные практические рекомендации по правильному уходу за лабораторным микроскопом. Продлите жизнь вашему лабораторному микроскопу и обеспечьте высокое качество исследований с этой подробной методичкой. Роман Овчинников делится своим многолетним опытом, предлагая:
* Практические советы по ежедневному уходу: От чистки линз до правильного хранения.
* Проверенные методики: Как сохранить оптику и механику в идеальном состоянии.
* Рекомендации, основанные на реальном опыте: Узнайте, как избежать распространенных ошибок.
Ваш микроскоп заслуживает лучшего ухода – получите его здесь!
Цена: бесплатно

Стерилизация в баклаборатории
Ключ к успешным и безопасным микробиологическим исследованиям – безупречная стерилизация. Эта методичка охватывает всё, что вам нужно знать:
* Методы стерилизации: Обзор современных и классических подходов.
* Оборудование: От автоклавов до фильтров – принцип работы и особенности.
* Режимы стерилизации: Практические рекомендации для посуды, сред и ПБА.
* Нормативные документы: Все, что нужно для соответствия требованиям.
Цена: бесплатно

Способы отбора и транспортировки клинического материала
Ваш гид по сбору и доставке клинического материала для бактериологических исследований. Это руководство поможет вам:
* Освоить отбор: Правильно выбирать и использовать расходные материалы.
* Понять транспортировку: Как применять транспортные среды и соблюдать условия доставки.
* Гарантировать точность: Обеспечить сохранность образцов для успешных исследований.
Практичные советы для вашей лаборатории.
Цена: бесплатно

Escherichia coli (кишечная палочка)
Лабораторная диагностика кишечной палочки E. coli. Клиническая значимость, культуральные свойства, микроскопия, биохимические тесты.
Цена: бесплатно

Moraxella nonliquefaciens (моракселла)
Лабораторная диагностика моракселлы. Клиническая значимость, культуральные свойства, микроскопия, биохимические тесты.
Цена: бесплатно

Чек-лист Что должен знать и уметь микробиолог для работы в лаборатории
Когда-то я сам только готовился стать микробиологом в баклаборатории. Я чувствовал неуверенность, т.к. не очень представлял, что меня ожидает.
Я надеюсь, этот чек-лист сильно поможет вам в подготовке к работе в баклаборатории. Хуже всего неизвестность. А благодаря чек-листу вы поймете, чего конкретно ожидать, к чему надо подготовиться.
Цена: бесплатно
Платные PDF-гайды

Мини-атлас “Микроскопия бактерий, окрашенных по Граму”
Уникальный атлас, составленный из реальных авторских фотографий. Именно так выглядят бактерии в микроскопе. Незаменимое пособие для тех микробиологов, кто только начинает свою знакомство с миром микроорганизмов. Правдивые и наглядные изображения, которые помогут в первичной идентифкации микроорганизмов.
Цена: 450 руб.

Топ-5 распространенных грибковых патогенов
Наиболее значимые возбудители микозов человека и животных, которые надо знать в лицо.
В этом PDF-гайде мы разобрали Топ-5 наиболее распространенных грибковых патогенов, их характеристики и особенности диагностики.
Цена: 300 руб.

Топ-10 бактериальных патогенов. Мини-атлас бактериальных колоний
Этот атлас – ценное пособие для начинающих микробиологов-практиков. В нем собраны 10 наиболее распространенных бактериальных патогенов, с которыми сталкивается каждый микробиолог. Эти микроорганизмы составляют 80-90% от всех видов, встречающихся в повседневной практике клинического микробиолога. В атласе собраны авторские фотографии бактериальных колоний на питательных средах, а также приведены базовые тесты для видовой идентификации.
Цена: 450 руб.

Ошибки в диагностике грибковых инфекций
Почему грибковые инфекции часто остаются не диагностированными? В последние годы грибковые инфекции, или микозы, стали предметом повышенного внимания в области медицины и ветеринарии. Несмотря на это, многие из них остаются не выявленными, что приводит к серьезным негативным последствиям для здоровья пациентов. В этом PDF-гайде мы разобрали основные причины, приводящие к диагностическим ошибкам как на уровне клиники, так и на уровне лабораторной диагностики.
Цена: 400 руб.

Стрептококки и энтерококки. Методические материалы для идентификаци
В данном буклете обобщены методические материалы для идентификации наиболее распространенных и клинически значимых стрептококков и энтерококков, включая виды Streptococcus pneumoniae, Str. agalactiae, Str. pyogenes, Enterococcus faecalis, Ent. faecium. Буклет содержит наглядные фотографии колоний этих возбудителей на питательных средах, фото микроскопии, а также диагностические лабораторные тесты.
Цена: 450 руб.

Candida albicans (Кандида альбиканс). Микробиологические характеристики
Candida albicans - пожалуй самый распространенный возбудитель грибковых инфекций. С ним сталкивается практически каждый клинический микробиолог, а потому необходимо знать характеристики, позволяющие идентифицировать возбудителя кандидоза. Гайд включает детализированное описание колоний, морфологических характеристик и специфических признаков, что существенно облегчает задачу идентификации кандиды. Гайд окажет практическую пользу микробиологам, занимающимся диагностикой микозов.
Цена: 350 руб.
Атлас клинически значимых дерматофитов (Р.С. Овчинников 2025)
Настоящий атлас содержит наглядные авторские фотографии культур грибов и микроскопические изображения, которые помогут лабораторным микологам в процессе видовой идентификации. Каждый раздел включает детализированное описание колоний, морфологических характеристик и специфических признаков, что существенно облегчает задачу диагностирования грибковых инфекций. В атласе представлены 15 наиболее распространенных видов дерматофитов, имеющих клиническое значение для животных и человека. Эксклюзивное издание, не имеющее аналогов на русском языке, окажет большую пользу микробиологам, занимающимся диагностикой микозов.
Объем 46 стр.
Цена: 1250 руб.

Асептика и дезинфекция в микробиологии
Асептика и дезинфекция в микробиологической лаборатории — ключевые меры для предотвращения заражения образцов и защиты персонала.
Асептика - это комплекс методов, исключающих попадание посторонних микроорганизмов в исследуемые образцы и среды. Дезинфекция - это уничтожение патогенных микроорганизмов на поверхностях, инструментах и отходах. В гайде разобраны оборудование, средства и методы, применяющиеся для этих целей в микробиологических лабораториях.
Цена: 500 руб.

Посев крови на стерильность (гемокультура)
Посев крови на стерильность представляет собой важный диагностический тест, применяемый для обнаружения наличия бактерий, грибков и других микроорганизмов в кровотоке пациента. Этот метод помогает выявить сепсис и другие инфекционные заболевания, характеризующиеся присутствием микроорганизмов в крови. В буклете разобрана техника посева и питательные среды для этих целей.
Цена: 400 руб.

Атлас клинически значимых грибов рода Candida (Р.С. Овчинников 2025)
Кандиды - наиболее часто встречающиеся грибы в практике лабораторного миколога. Настоящий атлас содержит наглядные авторские фотографии культур грибов и микроскопические изображения, которые помогут лабораторным микологам в процессе видовой идентификации. Каждый раздел включает детализированное описание колоний, морфологических характеристик и специфических признаков, что существенно облегчаетзадачу идентификации видов рода Candida.
Объем 75 стр.
Цена: 1450 руб.
Вас также заинтересует:

Самозянятый Роман Сергеевич Овчинников
ИНН 772973970875
г. Москва